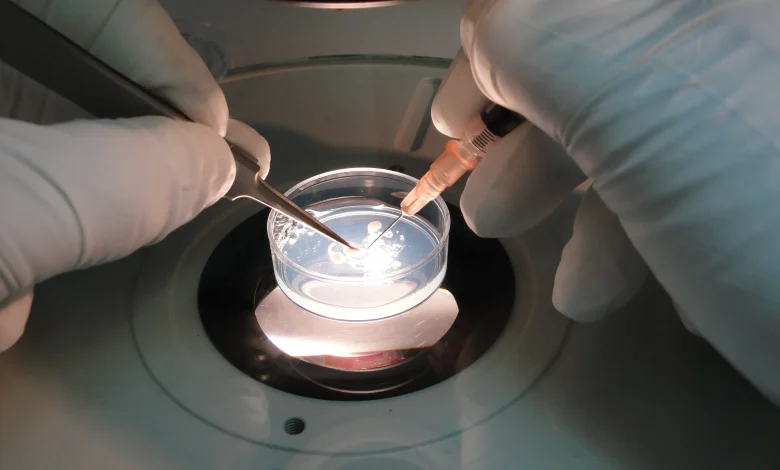
آزمایش اسپرم

آزمایش اسپرم چگونه انجام میشود ؟
مایع منی حاوی مقادیر زیادی اسپرم جهت باروری میباشد . بررسی اسپرم های تولید شده توسط آزمایش اسپرم یا اسپرموگرام جز قدم های اول در بررسی زوجهای نابارور است .ممکن است آزمایش اسپرم چند بار انجام شود تا نتیجه کافی حاصل شود .
بهترین زمان آزمایش اسپرم ؟
برای انجام آزمایش اسپرم بهتر است بین دو تا هفت روز قبل از انجام آزمایش انزال یا نزدیکی رخ نداده باشد (زمان ایده آل ۲۴ تا ۴۸ ساعت می باشد).چنانچه هر یک از شرایط زیر باشد بهتر است آزمایش اسپرم انجام نشود :
- مصرف کافئین، الکل، کوکائین، ماریجوآنا یا تنباکو
- سرد شدن نمونه منی. سرد شدن باعث کاهش حرکت اسپرم ها میشود و میتواند دقت آزمایش را کاهش دهد.
- مصرف داروهایی نظیر سایمتیدین، هورمونهای مردانه و زنانه (تستوسترون و استروژن)، سولفاسالازین، نیتروفورانتوئین و برخی دیگر از داروهای شیمیایی
- قرار گرفتن در معرض اشعه اکس، رادیوتراپی و مواد شیمیایی نظیر حشره کش ها و یا استفاده از کاندوم های محتوی مواد تاخیری و کشنده ی اسپرم و یا گرمای زیاد.
آزمایش اسپرم چگونه انجام میشود ؟
بهتر است نمونه با دست و با روش تحریک مصنوعی (masturbation) و بدون بکار بردن صابون یا مواد لغزنده کننده که می توانند اسپرم کش باشند تهیه شود. به هیچ عنوان از کاندوم برای جمع آوری نمونه نباید استفاده نمود. البته در برخی مراکز کاندوم های مخصوص بدون مواد آسیب رسان به اسپرم ها وجود دارد، که می توان با سهولت بیشتری نمونه داد. اگر نمونه با روش نزدیکی تهیه شود، احتمال آلودگی نمونه با ترشحات واژن و نتایج کاذب وجود دارد. دقت شود که تمام نمونه در ظرف ریخته شود و بهتر است با در دست گرفتن ظرف نمونه گیری دمای آن را به دمای بدن نزدیک نمود.
آزمایش اسپرم (اسپرموگرام ) در خانه چگونه انجام میشود ؟
در آزمایشگاه های مراکز ناباروری معمولا اتاق ویژه نمونه گیری در اختیار زوجین قرار می گیرد، اما اگر نمونه دادن در این مکان ها دشوار باشد، میتوان نمونه را در منزل تهیه نمود و کمتر از نیم ساعت در دمای بدن (ظرف نمونه چسبیده به بدن)، آن را به آزمایشگاه رساند.ظرف نمونه گیری باید از آزمایشگاه گرفته شود و کاملا تمیز باشد. دهانه ظرف نیز باید به اندازه کافی گشاد باشد. نمونه باید حداکثر طی یک ساعت پس از انزال مورد بررسی قرار گیرد.
حجم مایع منی ( EJACULATION VOLUME)در آزمایش اسپرم چقدر باید باشد ؟
حجم مایع منی باید حداقل ۲ سی سی باشد . حجم کم مایع منی میتواند به علت انسداد سیستم جمع آوری اسپرم ، کمبود هورمون اندروژنی و یا انزال رتروگراد(به عقب) مایع منی باشد.
مایع شدن سیمن یا منی ( LIQUEFACATION TIME ) در آزمایش اسپرم چیست ؟
مایع منی ، مایعی ویسکوز (کشدار) ، کدر ، سفید یا خاکستری و دارای بوی تند و زننده است و بلافاصله بعد از انزال منعقد (لخته) می شود .به طور طبیعی حدود ۲۰ تا ۳۰ دقیقه پس از انزال یا نمونه گیری، منی به حالت مایع تبدیل میشود و طولانی شدن زمان بیش از حد مذکور غیرطبیعی است و میتواند نشان دهنده ی وجود عفونت باشد .
رنگ مایع منی (APPEARANCE) در آزمایش اسپرم ؟
مایع منی از نظر رنگ باید نمای شیری رنگ باشد. زرد بودن یا نمای قهوه ای یا خونی غیرطبیعی محسوب می گردند.
PH مایع منی در آزمایش اسپرم ؟
PH مایع منی قلیایی و معمولا حدود ۷ تا ۸ می باشد . با گذشت زمان یا وجود عفونت PH مایع منی افزایش یافته و قلیایی می شود . بر عکس در مواردی که بیماریهای مزمن غده پروستات ، کیسه منی و اپی دیدیم وجود داشته باشد ، نمونه به طرف اسیدی شدن تغییر می کند.
تعداد نرمال اسپرم (SPERM CONCENTRATION) در آزمایش اسپرم ؟
تعداد اسپرم ها یا( Sperm count ) یا (Density): تعداد نرمال اسپرمها ۱۵ میلیون در یک سی سی مایع منی یا ۴۰ میلیون اسپرم در کل حجم انزال میباشد . اگر تعداد اسپرم ها کمتر از ۱۵ میلیون باشد الیگو اسپرمی و اگر تعداد اسپرم ها صفر باشد آزوسپرمی نامیده می شود.
ارزیابی تحرک اسپرم ( MOTILITY ) در آزمایش اسپرم ؟
پارامتر اصلی در تعیین کیفیت مایع منی ، تحرک اسپرمها است . چون اسپرمهای غیر متحرک قادر به عبور از مجاری تناسلی زن نبوده و نمی تواند تخمک را بارور سازد .در طبقه بندی قدیم چهار درجه بندی برای حرکت اسپرم ها در نظر گرفته شده بود که پس از مشاهده اسپرم ها در زیر میکروسکوپ برحسب میزان سرعت آن ها در این چهار گروه با معیار درصد بیان می شدند. که به صورت A و B و C و D یا ۴ و ۳ و ۲ و۱ تعریف می گردد. که A معادل ۴ بوده و به معنی حرکت سریع اسپرم ها می باشد. همچنین D معادل ۱ بوده و به معنی اسپرم های بدون حرکت یا immotile می باشد. در این تقسیم بندی حداقل حرکت A > 25% یا A+B > 50% باید باشد. کمبود حرکت اسپرم ها، آستنوسپرمی نامیده می شود.
در سیستم گریدینگ (درجه بندی) جدید سرعت اسپرم اهمیت کمتری دارد و این که اسپرم حرکت رو به جلو داشته باشد، در اولویت قرار دارد و حرکت اسپرم ها در ۳ گروه تقسیم میگردد:
- حرکت پیشرونده Progressive motility
- حرکت غیر پیشرونده Non progressive motility
- بی حرکت Immotile
در این سیستم درصد حرکت پیشرونده اسپرم ها (Progressive motility) حداقل ۳۲% و کل اسپرم های دارای حرکت باید حداقل ۴۰% باشند.
MORPHOLOGY یا شکل اسپرم ها در آزمایش اسپرم ؟
ارزیابی مورفولوژی بصورت کمی و کیفی بوده و شامل تشخیص اسپرمهای نرمال از اسپرمهای غیر نرمال و… است .شکل ظاهری اسپرم ها زیر میکروسکوپ معیارهای مشخصی دارد که توسط فرد ماهر یا دستگاه های کامپیوتری ویژه تعیین می گردد. درصد شکل طبیعی اسپرم ها در سیستم قدیمی حداقل ۱۴% و در سیستم جدید حداقل ۴% می باشد. اگر شکل اسپرم ها در نمونه ای کمتر از این اعداد باشد، تراتوسپرمی گفته می شود.
WBC در آزمایش اسپرم ؟
میزان طبیعی WBC یا گلبول سفید کمتر از ۱۰ در میلی لیتر است. مقادیر بیشتر از این مطرح کننده عفونت یا التهاب مایع منی بوده و لکوسیتوسپرمی نامیده می شود و نیاز به آنتی بیوتیک دارد .
RBC در آزمایش اسپرم ؟
در آزمایش اسپرم تعداد نرمال RBC کمتر از ۳ عدد است و در صورتیکه بدون افزایش WBC باشد ، نیاز به بررسی بیشتر با سونوگرافی وآزمایشات تکمیلی توسط متخصص ارولوژی یا فوق تخصص اورولوژی دارد .
VIABILITY یا VITALITYیا تست زنده بودن اسپرم ها در آزمایش اسپرم ؟
در مواردی که اسپرم ها بی حرکت هستند، برای بررسی زنده بودن آنها از روش های رنگ آمیزی های ویژه استفاده می شود. در سیستم قدیمی میزان زنده بودن اسپرم ها حداقل ۷۵% و در سیستم جدید ۵۸% درنظر گرفته شده است.
آزمایشگاه تخصصی دکتر صادقیان، مفتخر به اخذ ایزو ۹۰۰۱ و ایزو ۱۵۱۸۹ انگلستان، تحت نظر دکتر حامد صادقیان، متخصص پاتولوژی سرجیکال و کلینیکال، بالغ بر هزار مورد از آزمایشات مختلف را در زمینه های پاتولوژی، سیتولوژی و میکروبیولوژی، تحت پوشش قرار می دهد.
آزمایشگاه دکتر صادقیان طرف قرارداد بیمه های پایه و اکثر بیمه های مکمل درمان می باشد.
آدرس: مشهد – بلوارامامت – نبش امامت ۳۴ – ساختمان پزشکان امامت
شماره تماس: ۰۵۱-۳۶۰۱۷۸۵۱ و ۰۵۱-۳۶۰۱۷۸۵۲




